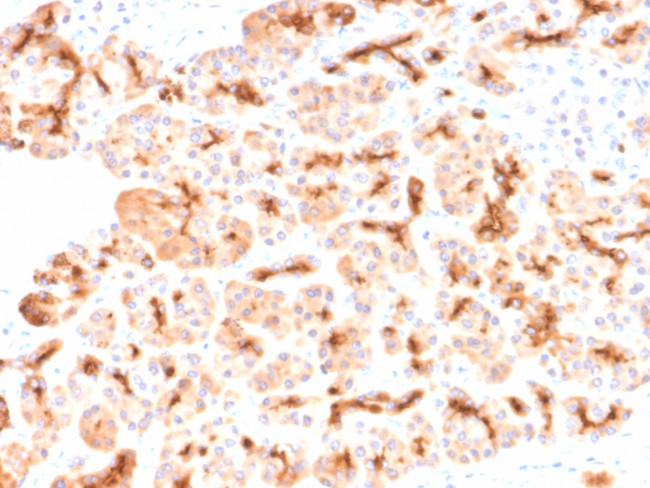
CFTR (Cystic Fibrosis Transmembrane Conductance Regulator) Antibody in Immunohistochemistry (Paraffin) (IHC (P))

Search
NeoBiotechnologies
CFTR (Cystic Fibrosis Transmembrane Conductance Regulator) Recombinant Rabbit Monoclonal Antibody (CFTR, 2290R)
{{$productOrderCtrl.translations['antibody.pdp.commerceCard.promotion.promotions']}}
{{$productOrderCtrl.translations['antibody.pdp.commerceCard.promotion.viewpromo']}}
{{$productOrderCtrl.translations['antibody.pdp.commerceCard.promotion.promocode']}}: {{promo.promoCode}} {{promo.promoTitle}} {{promo.promoDescription}}. {{$productOrderCtrl.translations['antibody.pdp.commerceCard.promotion.learnmore']}}
图: 1 / 2
CFTR (Cystic Fibrosis Transmembrane Conductance Regulator) Antibody (1080-RBM8-P1) in IHC (P)


Please note: We are reviewing Western blot images included in the antibody testing data in our catalog, including those provided by third parties. Unless expressly labeled or annotated as “raw-unedited”, Western blot images included in the antibody testing data in our catalog may have been edited, optimized or otherwise adjusted for presentation.
产品信息
1080-RBM8-P1
种属反应
宿主/亚型
Expression System
分类
类型
克隆号
抗原
偶联物
形式
浓度
规格
纯化类型
保存液
内含物
保存条件
运输条件
产品详细信息
Immunohistochemistry (PFA fixed): incubate antibody for 30 min RT. Staining of formalin-fixed tissues requires heating tissue sections in 10mM Tris with 1mM EDTA, pH 9.0, for 45 min at 95 degrees C followed by cooling at RT for 20 minutes.
靶标信息
Cystic Fibrosis (CF) is a common lethal genetic disease caused by mutations of the gene coding for the cystic fibrosis transmembrane conductance factor, a cAMP regulated chloride channel. Approximately 70% of all CF cases share the deletion of a phenylalanine at position 508 (delta F508) which results in abnormal chloride transport. Since the CF mutation is lethal, most often by lung and liver disease, it raises the question of why this genetic disease remains as common as it is. One possible explanation is that Salmonella typhi has been shown to use CFTR to enter intestinal epithelial cells and that delta F508 heterozygote and homozygote mice showed 86% and 100% reductions in S. typhi intestinal submucosal uptake.
仅用于科研。不用于诊断过程。未经明确授权不得转售。
篇参考文献 (0)
生物信息学
蛋白别名: ATP Binding Cassette Superfamily C Member 7 (ABCC7); ATP-binding cassette sub-family C member 7; ATP-binding cassette transporter sub-family C member 7; ATP-binding cassette, subfamily c, member 7; cAMP-dependent chloride channel; CFTR; Channel conductance-controlling ATPase; Cystic fibrosis transmembrane conductance regulator; cystic fibrosis transmembrane conductance regulator homolog; cystic fibrosis transmembrane conductance regulator homolog; ATP-binding cassette, subfamily c, member 7; tcag7.78; TNR CFTR
基因别名: ABCC7; AW495489; CFTR
UniProt ID: (Mouse) P26361
Entrez Gene ID: (Mouse) 12638